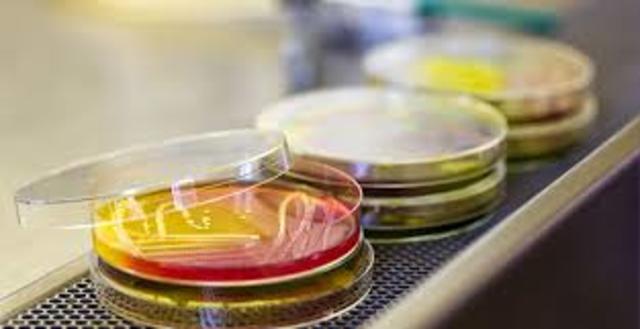
Decreto 2200 de 2005, Articulo 15.

-
Consiste en la capacidad técnica y administrativa, de los organismos encargados de evaluar y vigilar a cada uno de los integrantes del sistema de salud pertinentes; según sea su sector para así poder proporcionar un servicio idóneo, como lo establece la norma.
-
abarca Decreto 1280 de 2002
-
Dentro de los procesos farmacéuticos encontramos los procesos ESPECIALES; los cuales se enfatizan en las normas que deben cumplir las dosis prescritas de preparaciones magistrales y mezclas oncologicas de cada paciente. ya que se ve la necesidad de controlar y verificar dichos procedimientos.
-
El ministerio de la protección social en conjunto con el Instituto Nacional de Vigilancia de Medicamentos y Alimentos INVIMA; busca diseñar un programa en el cual se identifique los incidentes adversos y los riesgos de la salud publica, a la que se exponen los usuarios del sector salud , autoridades sanitarias y población en general. Buscando así reducir dichos incidentes.
-
Esta resolución tiene como objetivo, crear políticas de calidad a las empresas prestadoras del servicio de salud , buscando tener un control de las condiciones que deben cumplir cada una ellas; a través de la auditoria de la clasificación de los riesgos de los productos sanitarios que usan las entidades que usan estos productos.
-
este anexo busca que la entidad remisora haga cumplir con una evaluación de forma ordenada, sistemática y exhaustiva a la entidad territorial de la salud el cumplimiento de cada uno de los requerimientos establecidos en la norma.
-
la presente resolución tiene como objetivo crear un reglamento exigido para fortalecer la protección y seguridad de todas las personas que tienen contacto con los dispositivos médicos, mejorando así el servicio de la salud.
-
El objetivo de esta ley es que el INVIMA, actué como una Institución representante del proceso que tienen las materias sanitarias encuanto a su vigilancia y control de calidad de los medicamentos, alimentos, bebidas, cosméticos, dispositivos quirúrgicos y todos los que tienen un impacto en la salud individual y colectiva. Señalando de esta manera la necesidad de hacer cumplir dicha ley.
-
Regula la farmacovigilancia de medicamentos de uso humano; esta Ley trata a serca de las garntias que deben tener las entidades y el uso racional de medicamentos , dispositivos y productos sanitarios por lo que es de gran importancia estar presentes vigilando, el cumplimiento en cada una de las entidades donde usan dichos medicamentos y productos.
-
Vigilancia sanitaria; este decreto hace referencia a las personas encargadas del registro de un medicamento, el cual debe presentar e implementar un plan de gestión de riesgos y cumplir las buenas practicas de farmacovigilancia. Ademas de la importancia de incorporar tecnologías que permitan la señalizacion e identificación de su distribución.
-
este decreto trata acerca del procedimiento para la renovación y modificación de los registro sanitarios de los medicamentos de síntesis química y gases medicinales; el cual se efectúa presentando una solicitud de renovación que debe presentarse ante el registro sanitario para prevenir y asegurar el uso de dichos medicamentos, es necesario resaltar la importancia de este proceso ya que asi podemos obtener un buen servicio.
Plan projects on a visual timeline
Map milestones, phases, deadlines, and key events in one place so the sequence is easier to see and share. Timetoast is a timeline maker for work, school, research, and stories.